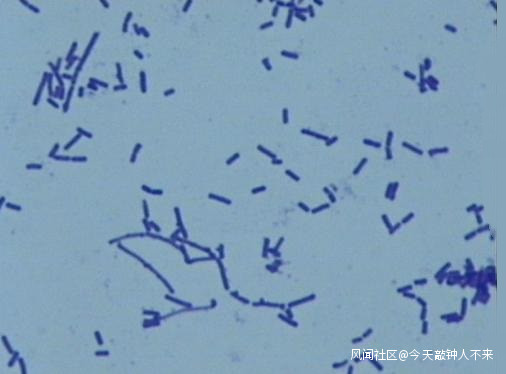

蘭州獸醫研究所多人疑似感染布病,這件事情先別慌!_風聞
今天敲钟人不来-2019-12-06 20:57
本文綜合,轉載聯繫。
日前,網絡上流傳着一則“中國農業科學院蘭州獸醫研究所多名學生疑似感染布魯氏菌病”的消息。
12月6日下午,蘭州獸醫研究所正式對外發布通報證實了此事。
通報稱,截至目前,共對該所263人次進行檢測,經甘肅省疾控中心確認呈現血清學陽性65人。血清學陽性人員中個別人員自感有身體不適現象,其餘人員未出現明顯臨牀症狀。
通報全文如下:
11月28-29日,中國農業科學院蘭州獸醫研究所口蹄疫防控技術團隊先後報告有4名學生布魯氏菌病血清學陽性。接到報告後,蘭州獸醫研究所立即派人陪同學生前往醫院診治,同時成立調查小組,關閉相關實驗室並開展調查。
截至目前,共檢測263人份,經甘肅省疾控中心確認呈現血清學陽性65人。血清學陽性人員中個別人員自感有身體不適現象,其餘人員未出現明顯臨牀症狀。
事件發生後,中國農業科學院第一時間啓動應急處置預案,派工作組赴蘭州指導和督促蘭州獸醫研究所做好應急處置等相關工作。國家衞生健康委員會、國家疾控中心、甘肅省疾控中心、甘肅省獸醫局、蘭州市衞生健康委、蘭州市疾控中心、城關區和七里河區疾控中心等多部門組成聯合工作組,設立流行病學調查組、治療專家組,到蘭州獸醫研究所開展流行病學調查,協調診斷治療。目前正在採取多項措施治療人員。
一、積極對血清學陽性人員進行診治。在首例陽性發生後,11月29日組織學生進行診治。陽性報告數量增加後,在甘肅省衞生健康委和蘭州市衞生健康委及疾控中心的協調下,邀請相關專家研究制定了治療方案,確定診治醫院,並開闢綠色救治通道,對學生進行檢查、診治。
二、配合衞生健康委認真追查疫源。收到報告後,封閉相關實驗室、實驗動物、動物舍,配合流行病學調查組調查40多人,配合調查組對動物房飼養實驗動物實驗室進行了取樣,對陽性人員用餐餐廳、研究所周邊飯館進行調查。目前,具體的疫源調查工作正在進行。
有新情況我所將及時發佈。
中國農業科學院蘭州獸醫研究所

公開資料顯示,所謂布病,即布魯氏菌病,也稱波狀熱,是布魯氏菌引起的急性或慢性傳染病,屬自然疫源性疾病,臨牀上主要表現為病情輕重不一的發熱、多汗、關節痛等,嚴重的話可能會導致不孕不育:男性病例伴有睾丸炎,女性病例可見卵巢炎。
因為是布魯氏菌是一種細胞內寄生菌,所以有可能導致患者終生攜帶病毒,是否復發情況不一。
我國出台的《傳染病防治法》中指出,布病是與結核、艾滋同等級的乙類傳染病。中國疾控中心官網信息則介紹,布病的臨牀表現是多種多樣的,病情輕重差異也較大,尤其近些年非典型病例頗不少見。

牧區工作人員對牲畜展開布病檢疫工作
據瞭解,相關傳聞最早是5日晚間出現在知乎論壇上。

知乎論壇的相關問題頁面截圖
某知乎用户在回答相關提問時爆料稱,11月中旬左右,蘭州獸醫研究所的幾名學生在做有關轉基因老鼠的實驗時,發現接受實驗的小鼠未懷孕,也就是實驗失敗。他們對小鼠進行解剖,發現小鼠感染了布氏桿菌。
這幾個人當即停止實驗,到醫院接受檢測,次日拿到的檢測結果顯示,有兩人的抗體呈現血清學陽性。
上述知乎用户繼續指出,所裏陸陸續續有學生的檢測結果呈現血清學陽性,到11月30日時已經有20人上下。但是研究所的態度除了表達一定的關切,組織學生到醫院進行檢測外,並沒有提供更多的幫助,導致了很多學生陷入恐慌。

不過對照知乎用户的爆料以及蘭州獸醫研究所的通報,還是發現存在着一定出入。
舉例而言,爆料網友稱,到12月5日,“據不完全可靠消息的統計,感染人數已經快上三位數了”;而蘭州獸醫研究所的通報則指出,同樣截止到12月5日,安排檢測後經甘肅省疾控中心確認呈現血清學陽性為65人。
與此同時,爆料網友認為如此規模的疑似感染情況,疫源很可能並不是接受轉基因實驗的小鼠。
蘭州獸醫研究所的通報同樣指出,他們正積極配合國家衞健委認真追查疫源,已採取的措施包括:封閉相關實驗室、實驗動物、動物舍,配合流行病學調查組調查40多人,配合調查組對動物房飼養實驗動物實驗室進行了取樣,對陽性人員用餐餐廳、研究所周邊飯館進行調查等。
研究所是否對於患病學生態度冷漠、沒有提供任何幫助更是具有一定的爭議性。
早前,傳聞還侷限在知乎平台時,站方曾經以“缺乏可靠信源”為由關閉問題(現已重新放出)。

一直到12月6日下午,澎湃新聞率先取得了中國農業科學院蘭州獸醫研究所診斷中心負責人的回應才讓傳聞得以證實。
不過在報道中,該中心的副主任林密強調:“從我的專業角度來説,現在不是説感染,只是布病抗體呈陽性,這跟感染是兩回事。”對於這樣的説法,風聞社區專欄作者@檸檬木聚糖 則認為,“這起碼算是暴露,而暴露就是有風險的”。
在這裏需要補充的是↓↓
血清學陽性,指的是RBPT(虎紅玻片凝集試驗)和SAT(試管凝集試驗)同時呈陽性。而在醫學檢測中,一般情況下,RBPT和SAT同時為陽性,且SAT(試管凝集試驗)效價≥1:100++,可以被確診布病。
但是相關檢測結果只能作為參考,是否確診還需要經過專業醫護人員的臨牀觀察。
説得更簡單一點,抗體呈陽性不代表發病,檢測結果符合了還得看有無相應的症狀。如果只是抗體陽性卻沒有出現任何症狀,這在醫學上稱之為隱性感染者。布病陽性的潛伏期一般2個星期,多也不超過2個月,潛伏期過了還是沒有症狀的話就不會發病了。

在澎湃新聞發出第一篇報道後不久,蘭州獸醫研究所進行了通報。
澎湃新聞傍晚時分又發出第二篇報道,其中透露,今天早上,研究所內多名學生因為擔心自己被感染,繼續在安排下到醫院或是疾控中心進行檢查。“大巴車50多個座位,基本上都坐滿了……做了一些常見的身體檢查,醫生開了利福平和四環素等抗生素藥物。”
早前一些檢測結果未顯示抗體呈陽性的學生,則有了暫時離開研究所的打算。
對於是否需要如此恐慌,風聞社區專欄作者@檸檬木聚糖 表示:
疑似染上布病的話,作為治療手段,臨牀上一般是做早期聯合抗菌,即聽從醫囑注射一定劑量的抗生素殺菌。關於預後,其實急症治癒相對可靠,但不能拖,國外有因為延誤治療而死於嚴重併發症的患者。
同時比較需要認真對待的復發問題,它嚴格意義上講是一種細胞內寄生菌,其躲避細胞滅殺的機制還不是很清楚,徹底滅殺是非常困難的。很多不會復發,但考慮到存在復發的病例,所以至少應該監測一年以上(可適當加倍延長)。
總的來説,布魯氏菌病可防可控,防控為主。主要預防措施就是遠離患病牲畜,已獲得的動物製品要經過嚴格消毒處理,食品類的最起碼要做熟再食用。
關於疫苗的問題稍微有些爭議,國際上有些國家支持,有些不,我國是支持給高危人羣接種的。疫區內經常接觸牲畜的朋友可以考慮一下,重點倒不是問接哪種,而是您在不在疫區(主要是豬、牛、羊,其次是犬、馬、駝、犛牛、馴鹿、水牛、野牛或海洋哺乳動物)。
如果懷疑患病,早發現早治療,不要過度恐慌,積極配合治療,越早治療效果越好。
(完)